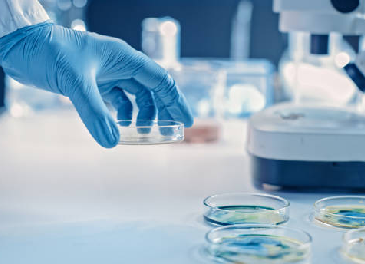

Objective insights for better mental health decisions.
Real-time, objective state signals to help people get help sooner.
Clinician-Led, Privacy-First
Research partners & advisory network
Consent-based pilots • Explainable models
Objective insights for better mental health decisions.
Real-time, objective state signals to help people get help sooner.
Clinician-Led, Privacy-First
Research partners & advisory network
Consent-based pilots • Explainable models
Everything about Mind-O-Gram
Everything about Mind-O-Gram
At Mind-O-Gram, we stand at the intersection of neuroscience and technology, dedicated to unlocking the power of brain and behavioral insights. By combining advanced EEG analytics, validated neuro-biomarkers, and privacy-first digital platforms, we bring clarity and precision to mental health care.

Research and Innovation
Mind-O-Gram drives neuro-behavioral progress through rigorous research and cross-disciplinary partnerships. We continually validate and refine EEG-based biomarkers, backed by transparent, peer-reviewed validation, converting brain signals into objective measures in real-world clinical settings that let clinicians identify risk earlier, tailor interventions precisely, and make confident, data-driven decisions at the point of care.

Mission and Vision
Our mission is to make objective brain-signal insights accessible and clinically reliable. We envision proactive, personalized mental-health care—enabled by privacy-first technology that helps providers act earlier, measure change, and improve outcomes for patients, families, and communities—responsibly.

Research and Innovation
Mind-O-Gram drives neuro-behavioral progress through rigorous research and cross-disciplinary partnerships. We continually validate and refine EEG-based biomarkers, backed by transparent, peer-reviewed validation, converting brain signals into objective measures in real-world clinical settings that let clinicians identify risk earlier, tailor interventions precisely, and make confident, data-driven decisions at the point of care.

Mission and Vision
Our mission is to make objective brain-signal insights accessible and clinically reliable. We envision proactive, personalized mental-health care—enabled by privacy-first technology that helps providers act earlier, measure change, and improve outcomes for patients, families, and communities—responsibly.

Advancing Care Through
Safe Real-World Studies
Our pilots are designed with rigorous ethics, clinician oversight, and privacy-first data handling—so objective insights can reach people safely and responsibly.
Validation Phases Explained
What each stage measures—from feasibility and capture quality to concordance and real-world impact.
Active Pilots
Where we’re collaborating with clinics and safety-critical programs to evaluate usability and outcomes.
Eligibility & Enrollment
Who can participate, consent requirements, and what to expect during baseline and follow-ups.
Clinician Resources
Guides, reporting examples, and integration notes for intake, monitoring, and care pathways.
Why Mind-O-Gram
Objective Signals That Lead to Earlier, Safer Decisions
Mind-O-Gram turns neuro-behavioral signals into explainable indices and trends, so care teams can act sooner and with confidence. Workflows are clinician-led and privacy-first—standardized capture, artifact checks, and consent governance keep results reliable from lab to real-world pilots.
Clinician-Led, Privacy-First
Consent/IRB workflows, secure data flows, and repeatable capture with quality checks.
Explainable Reports
Model cards, clear summaries, and PDF/API exports that fit existing hand-offs.


Driven by Science,
Committed to Mental Health
Pioneering objective neuro-behavioral insights with trusted clinical expertise, research collaborations, and privacy-first design.

Science-Driven. Patient-Focused.
We believe measurable brain and behavior signals can transform mental-health decisions—earlier, clearer, and more personal.
Real-Time Access to Objective Signals
Clinicians and programs receive up-to-date state estimates, risk/readiness indices, and longitudinal trends for ongoing care.
01
Clinical Impact Through Scientific Excellence
Mind-O-Gram advances care by uniting rigorous research, trusted partnerships, and scalable technology—so objective insights can reach patients, providers, and safety-critical teams around the world.
- We lead with research-driven innovation, turning validated EEG/wearable features into actionable mental-state signals.
- Our partnerships with hospitals, universities, and safety-critical programs accelerate discovery and real-world evaluation.
- Transparent methods—model cards, explainability, and continuous QA—support responsible clinical adoption.

Science-Driven. Patient-Focused.
We believe measurable brain and behavior signals can transform mental-health decisions—earlier, clearer, and more personal.
Real-Time Access to Objective Signals
Clinicians and programs receive up-to-date state estimates, risk/readiness indices, and longitudinal trends for ongoing care.
01
Clinical Impact Through Scientific Excellence
Mind-O-Gram advances care by uniting rigorous research, trusted partnerships, and scalable technology—so objective insights can reach patients, providers, and safety-critical teams around the world.
- We lead with research-driven innovation, turning validated EEG/wearable features into actionable mental-state signals.
- Our partnerships with hospitals, universities, and safety-critical programs accelerate discovery and real-world evaluation.
- Transparent methods—model cards, explainability, and continuous QA—support responsible clinical adoption.
- We lead with research-driven innovation, turning validated EEG/wearable features into actionable mental-state signals.
- Our partnerships with hospitals, universities, and safety-critical programs accelerate discovery and real-world evaluation.
- Transparent methods—model cards, explainability, and continuous QA—support responsible clinical adoption.
Every Stage Matters in Objective Mental-Health Care
Understand how Mind-O-Gram moves from research to real-world impact—through evidence, ethics, and responsible deployment.
Discovery & Preclinical
We isolate and vet brain- and behavior-based features for stress, mood, attention, and readiness. Bench studies check test–retest reliability, stability, and noise robustness. Standardized, artifact-screened capture is required before any clinical work.

Ethics & Regulatory Overview
Consent/IRB governance, privacy-by-design, and full transparency guide every step. From protocol design to data handling and reporting, controls are documented. Explainable methods and model cards make limits and use clear.

Clinical Pilots (Stage 1–3)
Stepwise pilots with clinical and safety-critical partners validate real-world fit. We measure concordance, usability, and workflow integration across sites. Outcomes, QA, and drift monitoring inform improvements before broader rollout.
FOUNDATIONAL RESEARCH & SIGNAL DISCOVERY

Discovery & Preclinical
We identify and validate brain- and behavior-based features that reflect stress, mood, attention, and readiness. Bench and lab studies establish reliability, test–retest stability, and artifact-robust capture before any clinical pilots.
Ethics & Regulatory Overview
We operate with strict consent, privacy, and transparency—from protocol design to data handling and reporting.

ETHICS, PRIVACY & GOVERNANCE (REGULATORY OVERVIEW)
CLINICAL & REAL-WORLD PILOTS (STAGE 1–3)

Clinical Pilots (Stage 1–3)
Stepwise evaluation with healthcare and safety-critical partners to demonstrate concordance, usability, and outcome impact.
Targeted Science. Real Impact
Better Minds.
Focused, evidence-led applications where objective neuro-behavioral signals create real-world value for patients, providers, and safety-critical teams.
Focused, evidence-led applications where objective neuro-behavioral signals create real-world value for patients, providers, and safety-critical teams.
Clinical Triage & Tracking
Earlier, clearer decisions in clinics and hospitals. Objective state estimates, risk/readiness indices, and longitudinal trends to support intake, care plans, and follow-ups.
Psychiatry & Psychology
An adjunct to interviews and scales. Helps monitor mood, stress, attention, and relapse risk over time—so clinicians can personalize therapy and medications.
Safety-Critical Readiness
For aviation, defense, and law enforcement. Periodic baseline and return-to-duty checks with fatigue/stress indicators and documented trends for supervisors.
Cognitive Health & Aging
Longitudinal signal changes that may reflect cognitive decline or recovery (e.g., post-treatment). Supports earlier attention and structured care pathways.
Addiction & Recovery Support
Objective patterns that can correlate with stress and lapse risk. Designed to complement counseling and MAT programs with continuous, privacy-respecting monitoring.
Youth & Education (Supervised)
Non-diagnostic, supervised use for attention/focus support and wellbeing programs. Trends help educators and families coordinate timely support.
Validation & Readiness
Trustworthy Signals, Ready for the Real World
Capture → features → explainable indices—each step is verified so it works in the field.

Deployment-Ready, Privacy-First
Mind-O-Gram transforms raw neuro-behavioral signals into clear, explainable outputs. Standardized capture kits, artifact screening, feature vetting, and consent/IRB governance ensure the results are reliable, transparent, and safe for use by clinicians and safety-critical teams.
Clinical & Research
- Standardized setup with QC & artifact screens
- Repeatability studies for session-to-session stability
- Concordance checks alongside clinician-rated instruments
- Consent/IRB workflows and quick start field guides
Engineering & Models
- Curated feature libraries reviewed on reference datasets
- Model cards (assumptions, ranges, limitations)
- Continuous QA & drift alerts in pilots
- PDF & secure API for EHR/ops hand-offs
Our Role
We provide the evidence and tooling—capture protocols, training, dashboards, and secure data flows—so decisions are faster and clearer. Diagnosis is always the clinician’s role; Mind-O-Gram provides decision support.
About us
IntegrityBiz is one of the world’s leading management consulting firms. We work with top executives to help them make better decisions, convert those decisions to actions and deliver the sustainable success they desire. For more than 40 years, we’ve been passionate about achieving better results for our clients.
We’ve worked with the majority of the Global 500, thousands of major regional and local organizations, hundreds of nonprofits, and private equity funds representing 75 percent of global equity capital.
About us
IntegrityBiz is one of the world’s leading management consulting firms. We work with top executives to help them make better decisions, convert those decisions to actions and deliver the sustainable success they desire.
We’ve worked with the majority of the Global 500, thousands of major regional and local organizations, hundreds of nonprofits, and private equity funds representing 75 percent of global equity capital.

Inegrity Biz In Numbers
Counting on Success: Explore our impressive track record of clients, projects, and success stories at IntegrityBiz.
Personalized Accounting Support for Your Business
At IntegrityBiz, we understand that no two businesses are alike. That’s why we offer dedicated accounting experts who will work with you to tailor our services to meet your unique needs. Whether you need help with bookkeeping, payroll, taxes, or more, our team is committed to providing you with the highest level of personalized support to help you achieve your business goals.


Customized Solutions to Meet Your Accounting Needs
We believe that accounting shouldn’t be a one-size-fits-all solution. That’s why we offer customized accounting solutions that are designed to meet your specific business needs. Whether you’re a small startup or a large corporation, our team of accounting professionals will work with you to develop a comprehensive strategy that maximizes your financial potential. From financial planning to tax preparation, our solutions are tailored to help you succeed.
What Our Clients Say

I've been using IntegrityBiz's bookkeeping services for several years now and have been extremely satisfied with their thoroughness and attention to detail. They have been a lifesaver!

I highly recommend IntegrityBiz's audit representation services. Their expert team helped me navigate a complicated tax situation with ease, and I couldn't have been more pleased with the outcome.

I recently used IntegrityBiz for my company's incorporation services, and I couldn't have asked for a better experience. They provided a seamless process and answered all of my questions along the way.

Always On Time
As our clients confirm, deadlines are sacred to us. Because of our reliable and strong-standing project management, we always deliver on time.

Great Communication

Dedication
To every project, we always assign a dedicated team which is fully focused on you and is not being distracted by other tasks.
Success Stories
From Struggling to Thriving: Discover How Our Expert Accounting Services Fuel Business Success
industry
Lorem Ipsum is simply dummy text of the printing and typesetting industry. Lorem Ipsum has been the industry’s standard dummy text eve
Press Release
Still Confused About Our Features? Get A Consultation
Let us help you navigate our accounting services and features. Schedule a consultation with our expert team today and get all your questions answered at IntegrityBiz.
